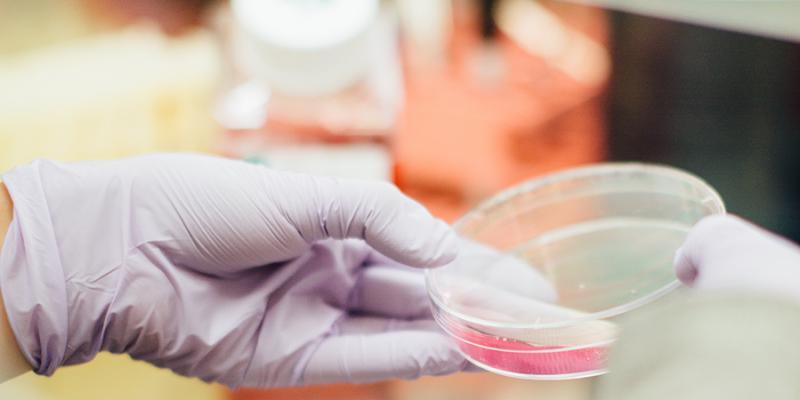
重疾险对白血病的理赔条件,白血病最终赔付

这几天被《我不是药神》这部电影刷屏了,4 天 13 亿的票房。
老实讲,我并不是一个喜欢凑热闹的人,对于人人都爱去看的片子,比如之前热映的阿凡达、战狼等,我都没去凑热闹。
无奈《我不是药神》实在太火了,火到我太太这种挺着大肚子的孕妇,不顾行动不便,也要去电影院观看,而且我作为保险从业者,医疗和保险相关性太大了,所以这部片子不得不看。
故事其实很简单,大体如下(轻微剧透):
慢性粒细胞白血病,只有格列卫这种药才能治,2013 年以前,吃这种药一个月要2万,一年仅吃药就得 20 多万。
要么吃药,要么就只能等死。有的人倾其所有,卖房吃药,也就坚持个 2-3 年,有的人为了不连累家人,吃了半年就选择自杀,有的妈妈为了孩子,不得不出卖自己的肉体。
由于印度特殊的政策,全球几乎只有印度才有格列卫的仿制药,药效基本一样,价格从每盒 2 万多降到几百块,徐峥饰演的主人公选择*私走**印度仿制药,最后被捕。
这就是这个故事的梗概,里面不仅掺杂了人性,还有对当下医疗制度的深思。看完电影,我几个小时没闲着,一直在查看各种资料,这里分享大家最关心的一些感想。
一、药价贵得离谱,凭什么?
格列卫作为一种划时代的药物,给患者希望的同时又因为价格让人绝望。可能有些人会好奇,药价凭什么这么贵?
贵的理由 1:研发投入巨大
研发一种特效药的风险也是很大的,很可能投入了巨资,但是最后项目失败了。
2014 年,美国塔夫茨大学药物发展研究中心报告显示,开发一种新的处方药,平均成本已经达到了 26 亿美元。
而且药品的专利期一般是 20 年左右,如果上市后的十几年后,并不能高价收回成本,那么等专利期结束了,所有人都可以自由生产,所以在专利保护期内,药品价格都非常贵。
药的价格贵,不是道德的问题,是商业的问题,不仅中国人买不起,美国人也同样买不起。
贵的理由 2:国内流通环节的隐形成本
2015 年 1 月,人民网的跨国调研发现,格列卫在中国大陆的零售价格最高,不仅高于原产国,也高于欧美发达国家,价格甚至是邻国韩国的两倍。
同样的药品,为什么就比别人贵?
重新临床试验:即使在国外已经上市多年的特效药,如果要在国内销售,就必须进行临床试验,每一期的临床试验成本大约是 300-700 万美金。而国内一些以**药酒为代表的「副作用不明」、「药理机制不明」的药,却都卖得还不错。
税和隐形成本:进口药还有税以及医院等各种流转过程中的费用,同样也导致了药品价格过高。
注册方面要和药监总局打交道,药价上要和国家发改委打交道,进医保要和劳社部打交道,进医院要和各地招标办以及医院的院长、药剂科主任打交道。“上下打点”的成本占药价多少,虽然没有精确数字,但占比非常之大。

而据 2013 年人民日报的调查报道发现,治疗乳腺癌的赫赛汀,在大陆要卖 24500 元,而香港药房的最低报价约合人民币 14800 元,一江之隔,每盒药价格相差近一万元。
香港没有 5% 的关税和 17% 的增值税,没有 15% 的医院加价,流转费用也不会达到 20% 多。
还是那句话,药价贵不是道德问题,里面涉及的因素有很多。想起刚被发明出来的青霉素,同样比黄金还贵。
商业是最高的道德,只有药厂有动力,才能去开发这种特效药,说了这么多,希望大家不要被电影中药厂的负面形象所误解。
二、得了白血病,我该怎么办?
说完药的问题,我们再聚焦一下主人公患有的病,慢性粒细胞白血病。
如果不幸得了这种病,那可怎么办?

作为保险行业垂直媒体,深蓝君能提供的解决办法,还是要靠保险:靠国家医保和商业保险。
1、商业保险怎么赔?
关于白血病深蓝君之前就有深入的分析了,我们都知道,白血病就是血液系统的癌症,是恶性肿瘤一种。
恶性肿瘤
指恶性细胞不受控制的进行性增长和扩散,浸润和破坏周围正常组织,可以经血管、淋巴管和体腔扩散转移到身体其它部位的疾病。经病理学检查结果明确诊断,临床诊断属于世界卫生组织《疾病和有关健康问题的国际统计分类》(ICD-10)的恶性肿瘤范畴。
下列疾病不在保障范围内:
原位癌;
相当于 Binet 分期方案A期程度的慢性淋巴细胞白血病;
相当于Ann Arbor分期方案I期程度的何杰金氏病;
皮肤癌(不包括恶性黑色素瘤及已发生转移的皮肤癌);
TNM 分期为T1N0M0期或更轻分期的前列腺癌;
感染艾滋病病毒或患艾滋病期间所患恶性肿瘤。
慢性粒细胞白血病属于恶性肿瘤,并不在免责范围,所以如果买了重疾险,不幸罹患慢粒,是可以按照重疾险来赔的。

在《白血病保险,值得买吗?》中,深蓝君对四大类白血病进行了常见分类:

所以只要买了重疾险,就可以获得全额赔付,只要你的保额高 ,凭借理赔款就算吃进口药,也能挺个几年。
深蓝君之前一直在强调保额的重要性,在《买保险就是买保额》这篇文章中,我们已经强调得很清楚了。
2、百万医疗险,怎么赔?
在之前的测评文章中,深蓝君已经提到过,对于住院医疗险来讲,非住院期间服用的靶向药可以通过特殊门诊责任报销,有的产品有这个责任,有的是没有的,在挑选的时候需要注意。
很多医院受制于医保政策,这类药库存并不多,需要到指定药房购买。而现在支持外购药的医疗险明显不多,绝大多数产品都是不支持的。
所以医疗险有用,但是具体有多大作用,还是要结合实际情况来分析。
3、国家医保,怎么赔?
无论在任何文章中,深蓝君都一直在强调国家医保的重要性,无论是职工医保(看测评)、居民医保(看测评)、还是新农合(看测评),有总比没有强。

而且随着国家对医保的改革,今年开始很多省市已经执行了新的医保政策,很多治疗癌症的特效药已经纳入医保目录,常见的肺癌、胃癌、结直肠癌等都有覆盖。
很多肺癌患者用的靶向药易瑞沙,以前年均药物费用约 18 万,而纳入国家医保目录后,自费仅需 1.7 万左右,相当于药费打了 1 折….
之前很多人明知道有更好的副作用更小的药,但是迫于经济原因,却不得不使用其他便宜的传统治疗方法,起码 部分省市 的朋友可以放心使用,在《父母退休,如何跨省就医?》一文中,深蓝君已经有了详细的分析了。
但所有的价格奇高的抗癌特效药,都纳入医保,就是一件好事吗?
未必,医保基金就那么多,如果纳入多一种疾病,就会对另外一些患者产生影响。盘子大小是一样的,花在抗癌特效药上面的钱多了,花在其他疾病时就会减少。所以看似简单的的问题,背后还有复杂的计算和博弈。
三、关于贫穷:
影片中一位假药贩子说了一句刺骨的实话:世界上只有一种病,就是穷病。其实这句话对我的触动非常大。

大家知道我是一个东北人,上大学前 18 年,我完全在东北长大。从小到大,我看到了很多又穷又懒的例子,很多人不思进取安于贫困,好像穷的很有理一样。
举个例子,我爸爸在退休后会找一些兼职来做,不仅能打发时间还能多一些额外收入,就这样都会被一些人嘲笑,就好像我们做了亏心事似的。
11 月之后,东北就被白皑皑的积雪覆盖,长达 4 个月的时间里,大家都在猫冬,不少农民就是抽烟喝酒打麻将过日子,多少人力资源被荒废,想想就有点可怕。
同样的,就算有印度药仿制药,很多人说自己不懂汇款、不懂英文、网上写的流程也太复杂了,而求助故事原型中主人公的帮忙,这里深蓝君原文引用:
陆勇颇有些怒其不争,“这些患者实际上也是对自己不负责任,因为你这个病是长期服用的,你绝对不能依赖人家,”他说,“你买个手机都要花半天的时间看看它是不是好的,对你人生非常重要的事情,你怎么能够随便看了十分钟以后,马上就说我搞不懂什么东西。”
格列卫一个月 2.4 万元,制药公司 2003 年 12 月在中国上市伊始,就和国内的慈善总会合作赠药,买三赠九,综合平均下来一个月 6000 元,对于部分城市家庭也许还能负担,但是对绝大多数农村家庭来说这是不可承受之重。
所以无论怎么降价,始终有一部分人是吃不起的。

每个人的收入不同,一张 100 块对不同人的意义完全不一样。建议大家还是不能懈怠,买好保险多多挣钱,尽早实现财务自由,我觉得才是务实的王道。
一个小小的电影,折射出很多无奈的现实,虽然我们国家整体有钱了,但是很多核心行业还是很落后,比如芯片、制药、甚至是电影都做不过印度宝莱坞。
黑格尔说过,真正的悲剧不是出现在善恶之间,而是出现在两难之间。
希望大家都不要经历要么病死,要么穷死的困境。作为个体来讲,我们还是要提高自己的抗风险能力。
命是自己的,成年人要对自己负责。
一起共勉。
